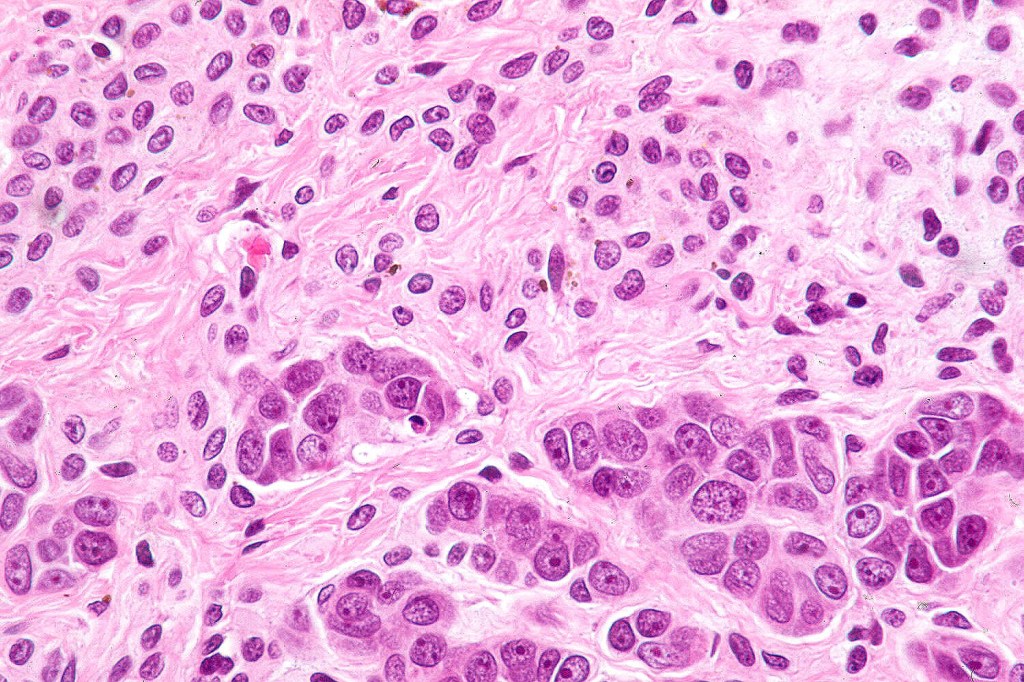
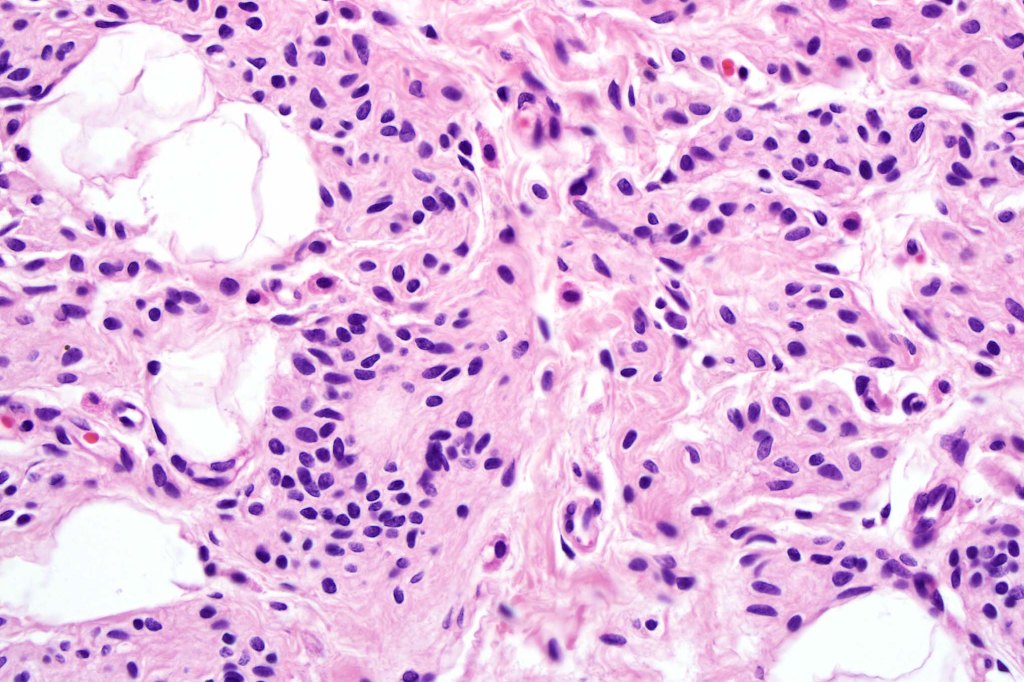
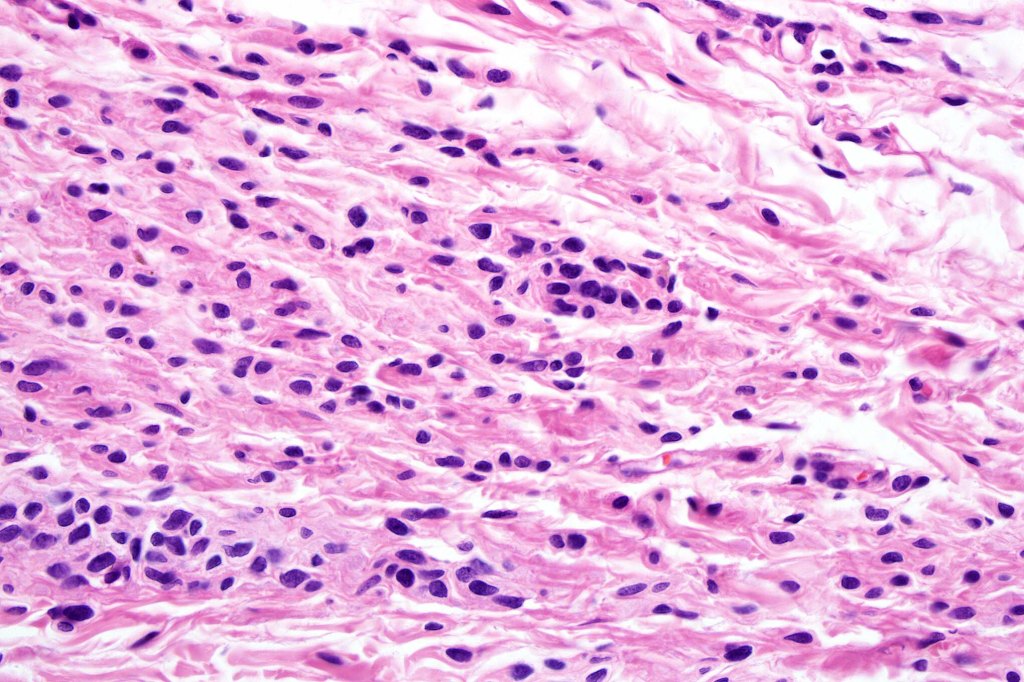
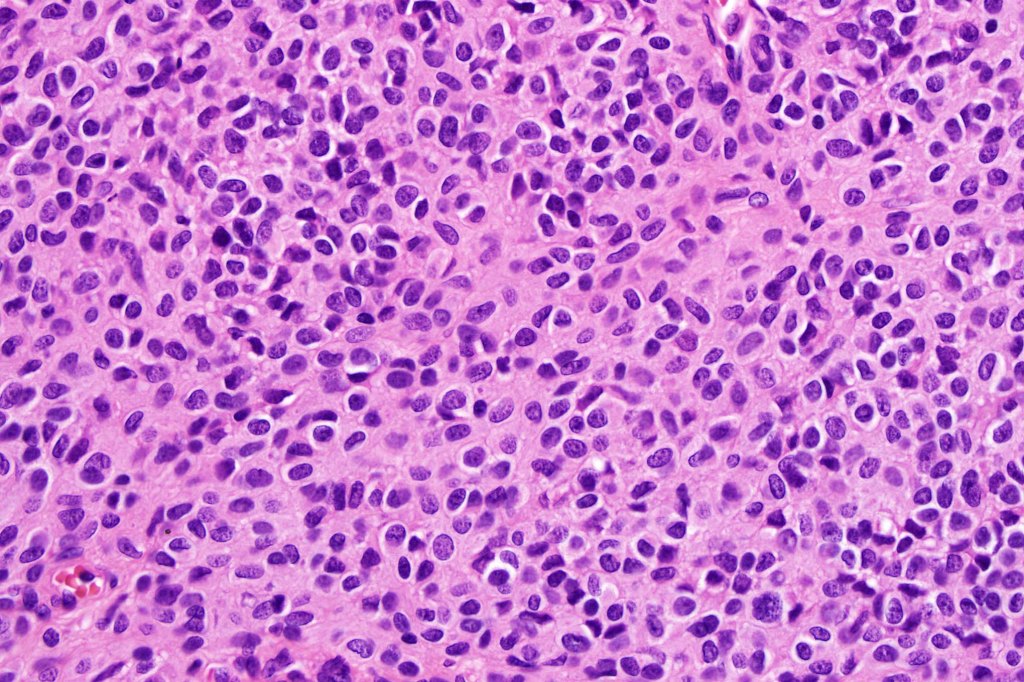
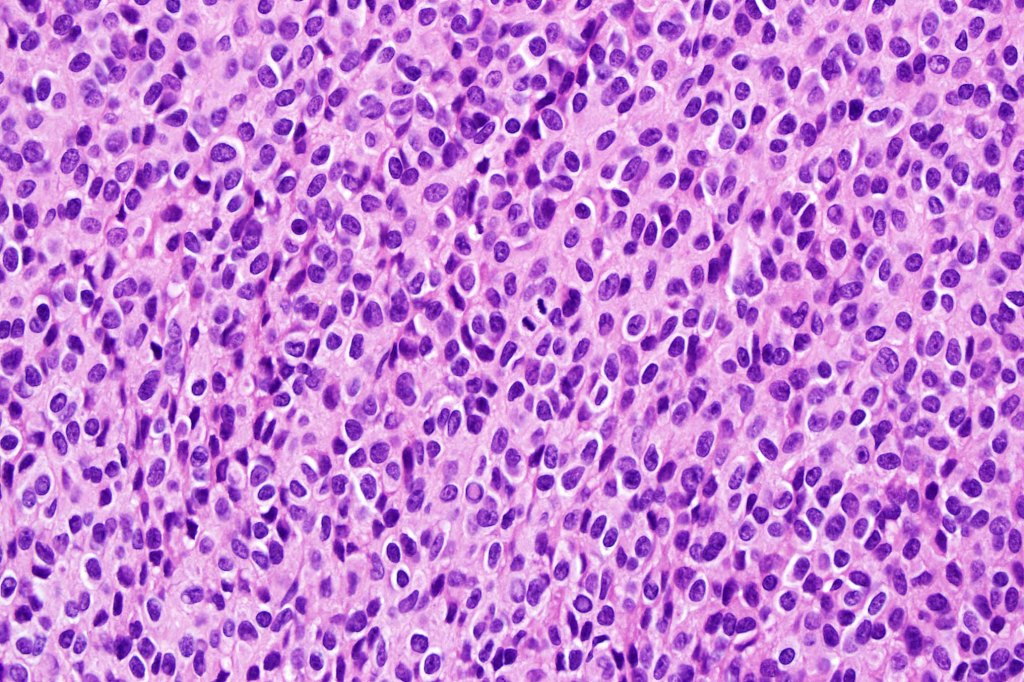
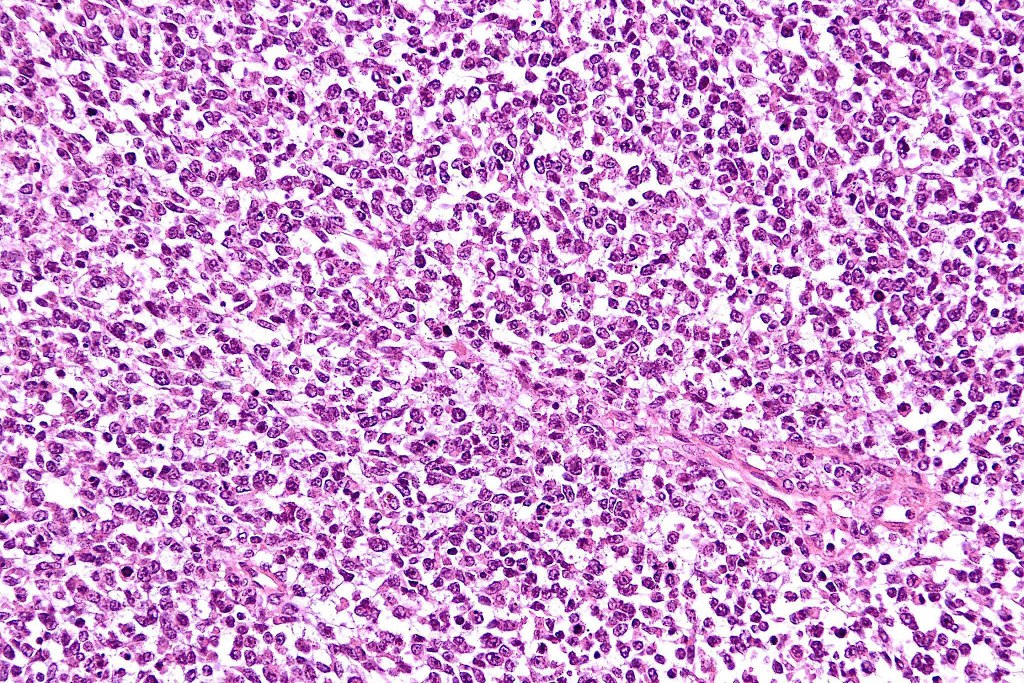
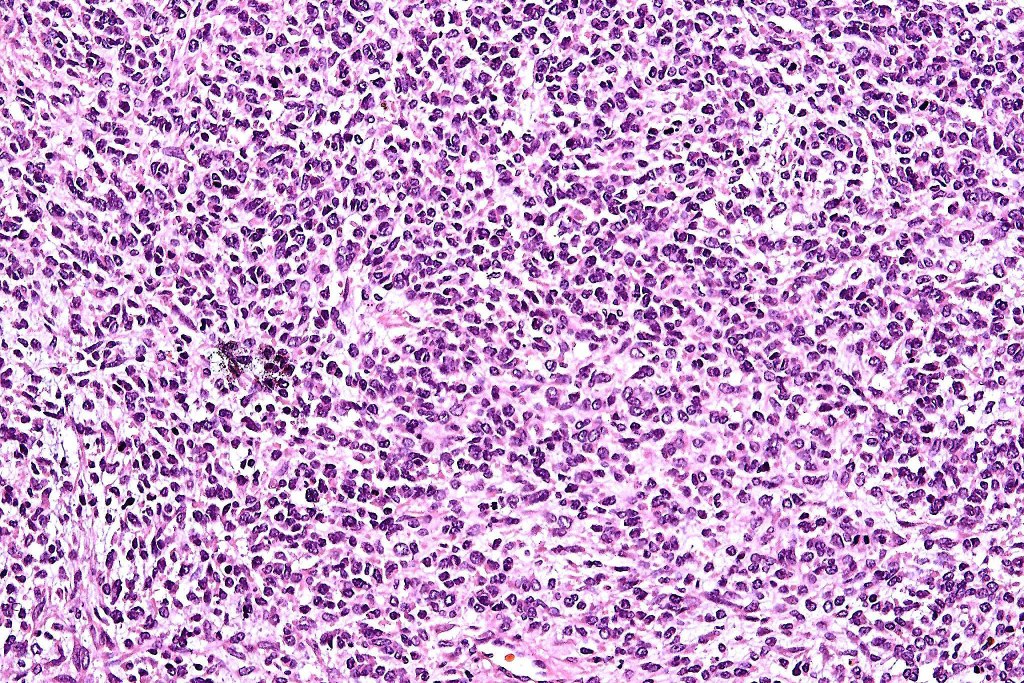
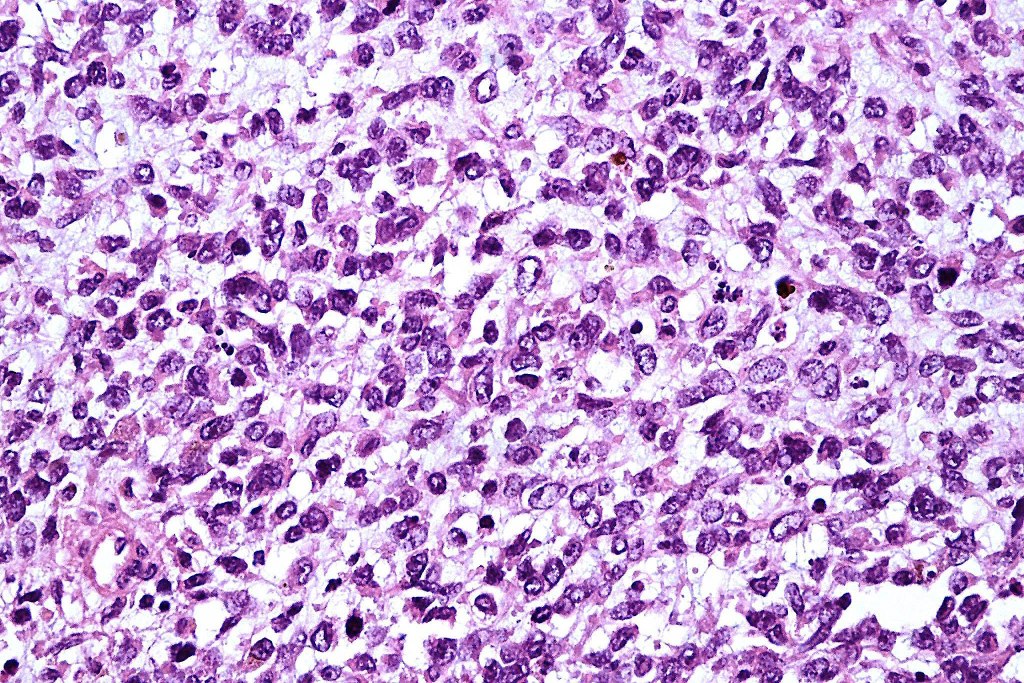
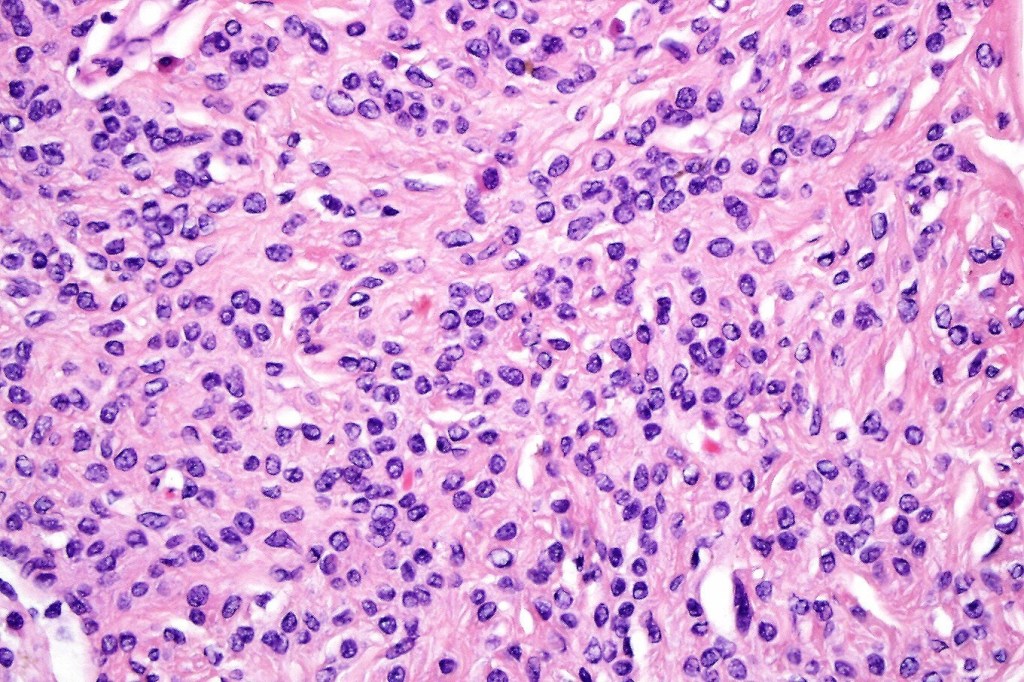
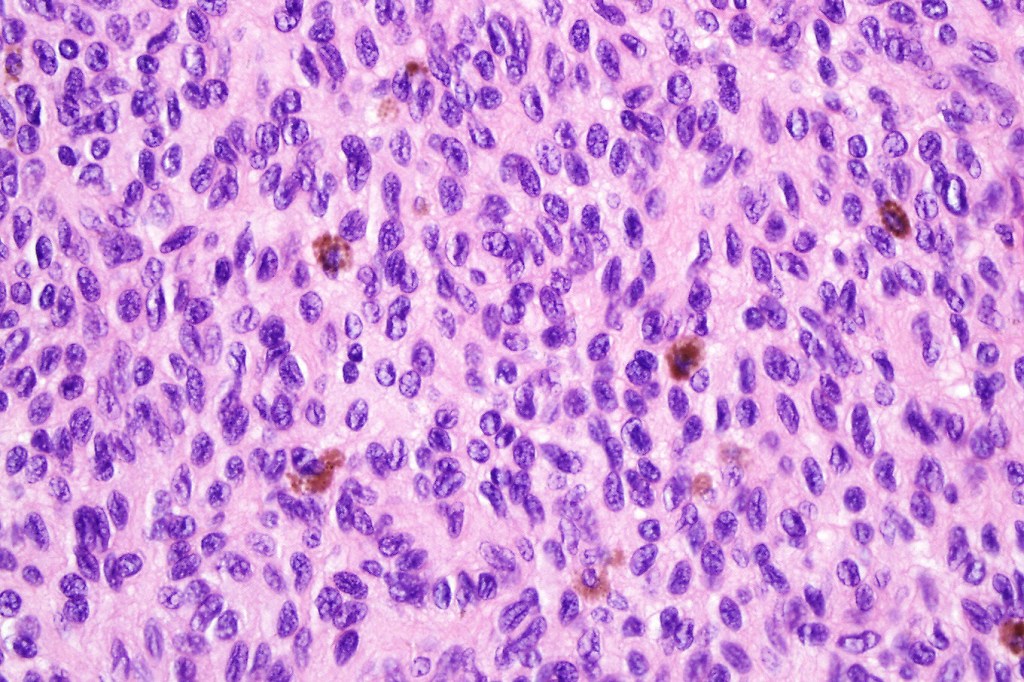
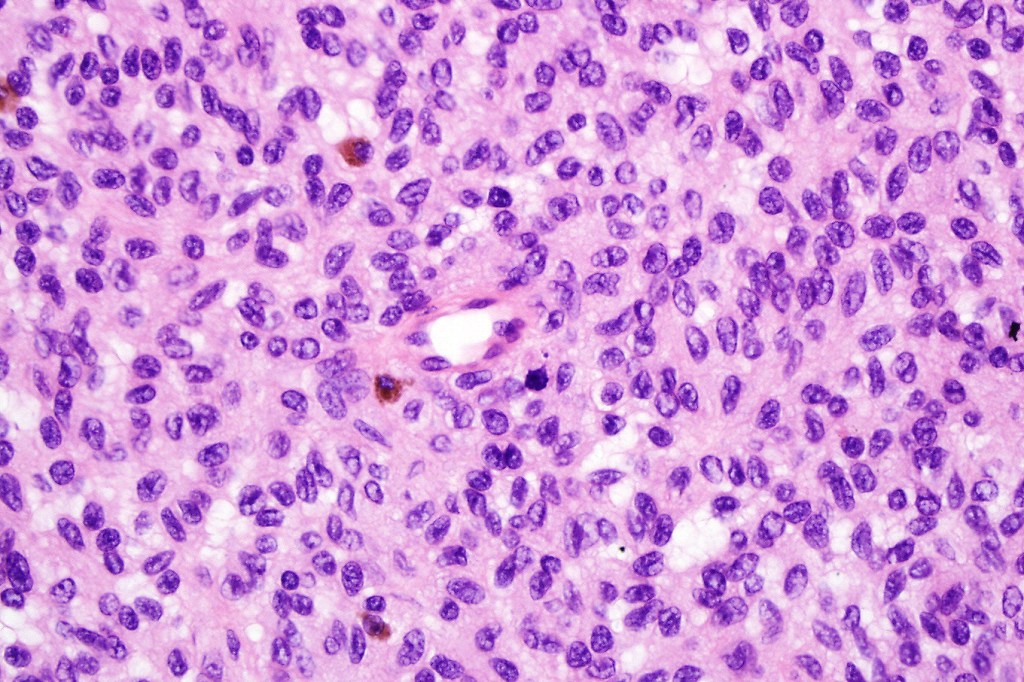
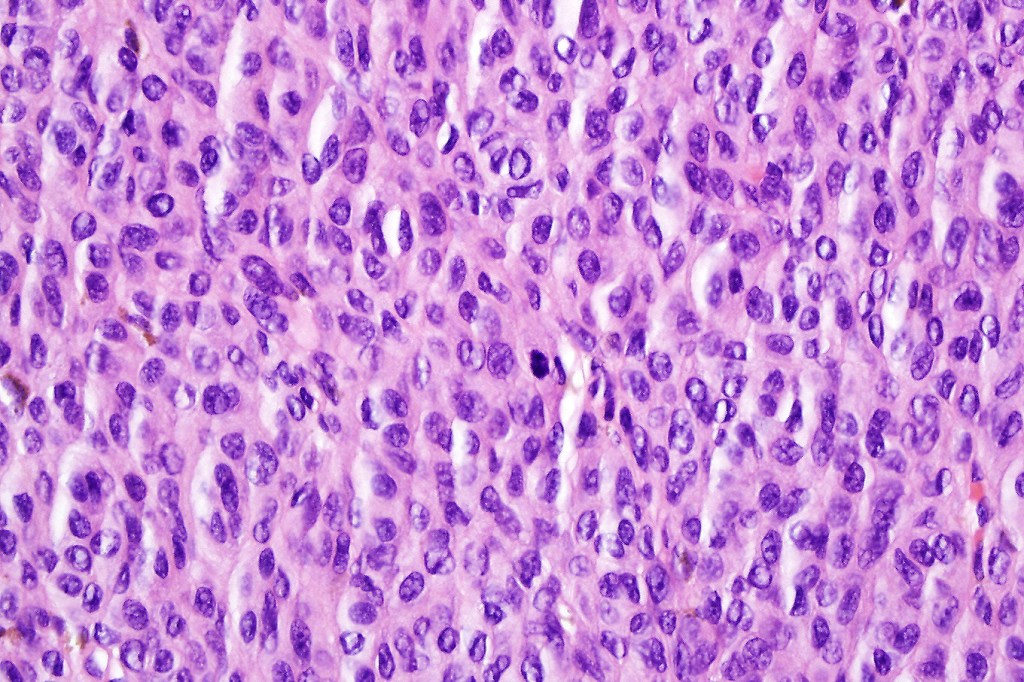
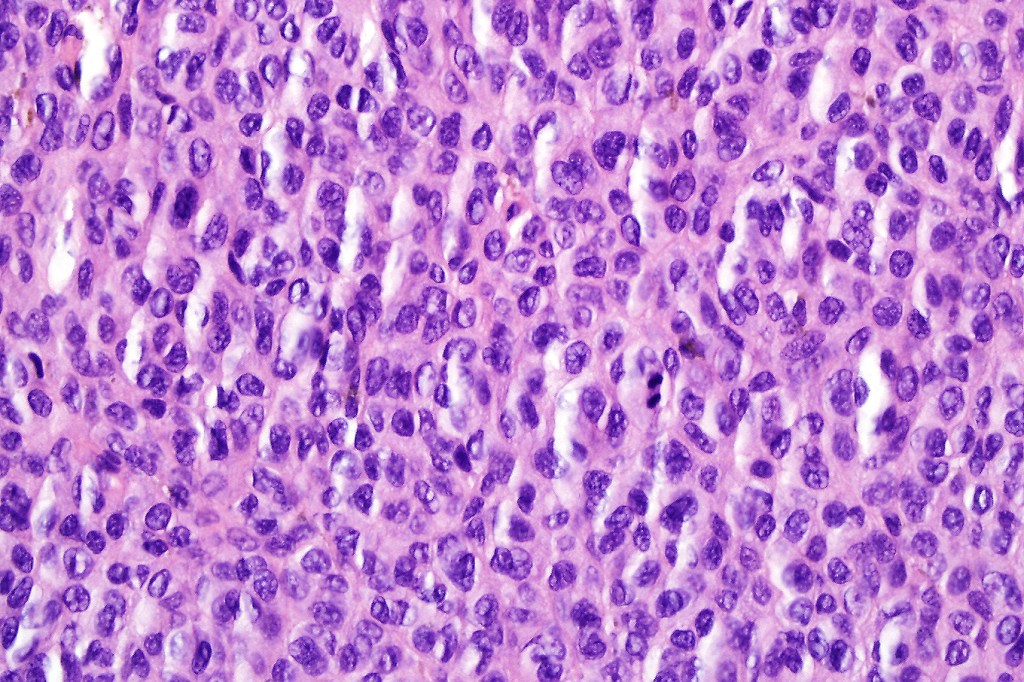
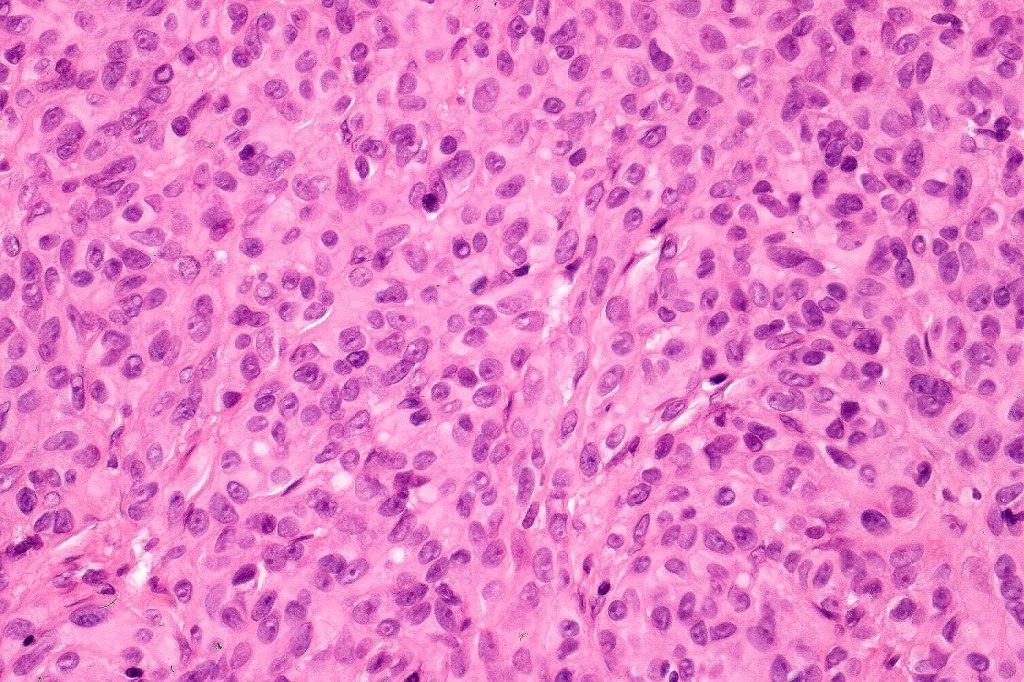
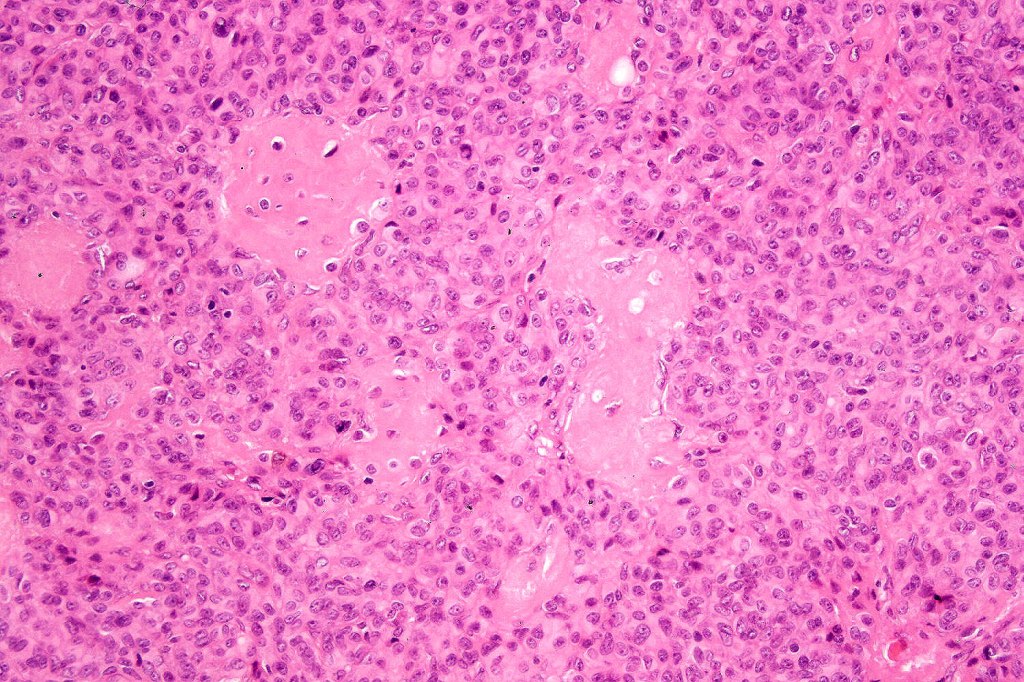
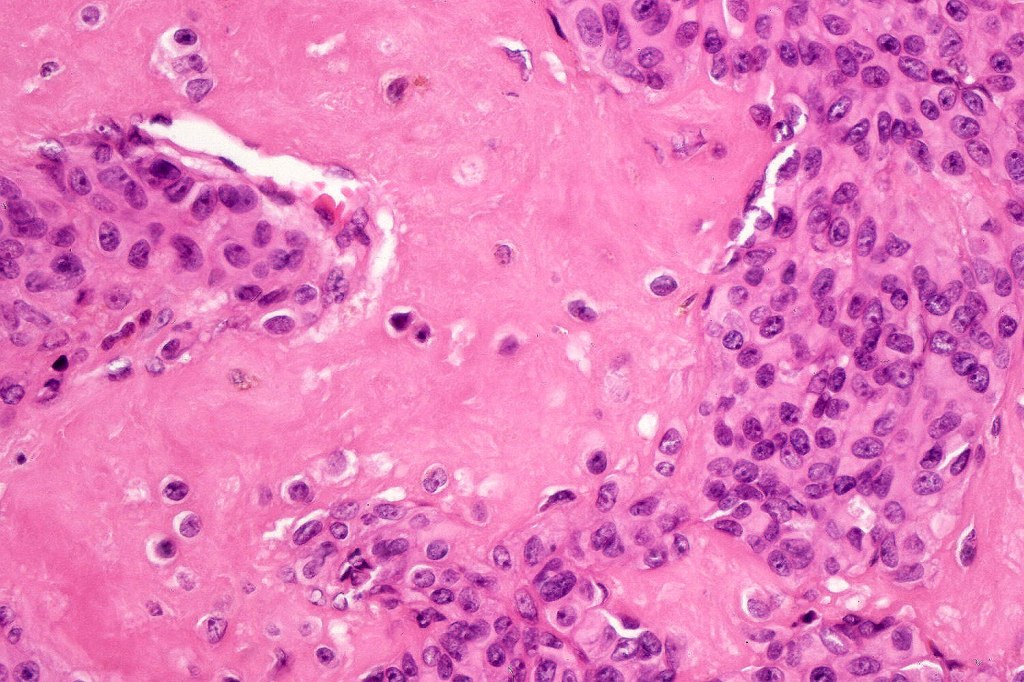

Clinical features
•Proliferative nodules arise in giant (& occasionally small) congenital nevi
•Develop in 2.9-19% of giant congenital nevi
•Lesions can be single or multiple & are generally present at birth
•Coloration varies from brown to black although deep seated lesions may not be apparent to the naked eye
•The natural history is of spontaneous regression
•Their importance is that they may be misdiagnosed by the unwary as neonatal melanoma
•Congenital & neonatal melanoma is vanishingly rare
•Similar lesions have been described in adults
•Clinical presentation includes papules, nodules & plaques
•Size is variable, although most are around 1.0 cm in diameter, on occasions very large nodules are encountered, ulceration may be present in large nodules
Clinical photographs courtesy of Dr. Niamh Leonard


Histological features
•The nodule generally merges with the adjacent nevus but sometimes it can be sharply circumscribed
•It is hypercellular and most often composed of epithelioid cells showing little pleomorphism & only occasional mitoses
•Nuleoli are small
•Intracytoplasmic pseudo-inclusions
•The constituent cells are generally larger than the adjacent nevus cells
•Some examples show more marked pleomorphism with prominent nucleoli and increased mitotic activity but abnormal mitoses are not a feature. These are not associated with any sinister biological potential
•Absence of necrosis, hemorrhage or Pagetoid spread in the overlying epidermis
•Spindle cell, small blue cell, blue nevus-like features, Spitzoid & proliferative nodules with mesenchymal differentiation (myofibroblastic, chondroid & osteoid) can be seen

Leave a comment